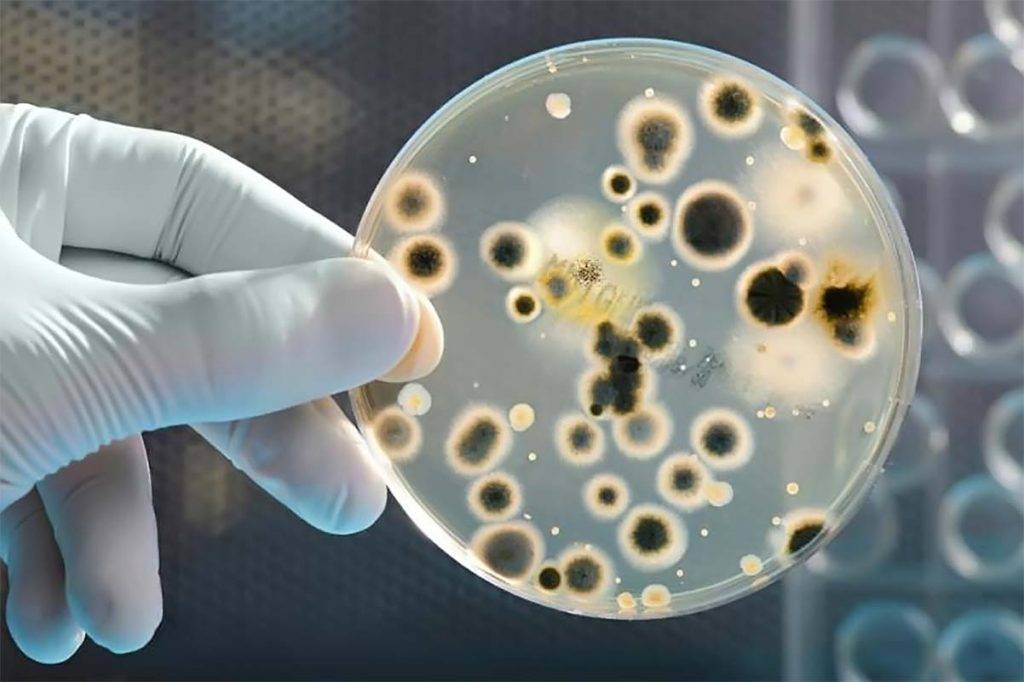

Что нужно знать о биобактериях для канализации
Они делятся на два вида:
- аэробные – живут и питаются в присутствии кислорода;
- анаэробные – могут обитать только в безвоздушной среде.
Использовать такую систему очистки можно, но тогда жидкость на выходе приходится доочищать механическими фильтрами.
В настоящее время они обитают только в придонном иле, болотах, глубоких слоях почвы. Разлагая остатки животных и растений, микробы расщепляют их на метан и минеральный осадок и «изготавливают» гумус – плодородный слой почвы, а также торф.
Консервирование – молочно-кислое брожение, к которому относится квашение, изготовление силоса. Живут они в жидкой среде.
Аэробам кислород необходим – если они оказываются в замкнутой емкости, то нуждаются в подкачке воздуха извне. Живут во влажных и жидких, насыщенных кислородом средах и очень боятся антибиотиков, агрессивных чистящих средств, хлора. Из-за этой особенности первый удар в очистке принимают анаэробы, а дальнейшую обработку осуществляют уже аэробы – т. е. очищение идет по комбинированной схеме.
Особенности септиков в зависимости от материала
Септики могут быть сделаны из разных материалов. Обычно материал тоже зависит от типа септика.
Пластиковый — один из популярных и наиболее герметичных вариантов. Производители заявляют, что срок службы таких септиков — до 50 лет.
Кирпичный септик — простое решение для дачи, у которого могут быть проблемы с герметичностью. Если нужен водонепроницаемый септик из-за высокого уровня грунтовых вод, лучше рассмотреть другой вариант.
Железобетонный обычно представляет собой колодцы из колец. Популярный вариант для организации септика-отстойника. С точки зрения герметичности лучше кирпичного, но хуже пластикового. Многое зависит от качества сборки и материалов, использованных при установке.
Металлический септик не пользуется популярностью по нескольким причинам. Соразмерный септик из металла значительно тяжелее пластикового, а значит, доставить и установить его будет сложнее и дороже. Кроме того, даже обработанный металл больше подвержен коррозии, чем пластик. Это может привести к разгерметизации и загрязнению почвы. Септик из металла прослужит меньше пластикового.
Комбинированные варианты тоже встречаются. Например, камера-отстойник из пластика с бетонным кольцом для дренажа очищенной воды в почву. Появляются и септики из новых материалов, например из стеклопластика. Такой септик прочнее и легче пластикового, а срок службы может превышать 50 лет.
Факторы, снижающие эффективность живых бактерий
Применяя биоактивный препарат, надо понимать, что есть факторы, которые могут сократить результативность.
Среди них:
- Нечастое применение канализационной системы. Если отходы, требуемые для обеспечения жизни микробактерий, перестают поступать, то живые микроорганизмы могут умереть. Обычно нельзя допускать простоя канализации более 1,5-2 недель. Совет: если в частном доме семья живет только летом, то нужно взять специальные добавки, используемые при длительной консервации септиков. При применении этого средства в весенний период объём активного ила нормализуется в разы активнее.
- Поступление в канализационную сеть на даче средств бытовой химии, в составе которых присутствует хлор. Применение порошков для стирки и чистки с антибактериальными спецдобавками может спровоцировать угнетение колонии микробактерий. Если на даче часто применяются посудомойка и стиралка, то в качестве биологически активной добавки нужно выбирать препарат для коммуникаций с соответствующей пометкой, активные элементы которого могут выживать и в агрессивной среде.
- Применение фильтров для питьевой воды, которая подается из скважины или водопроводной системы. При промывании таких фильтров в канализационную сеть могут попасть вещества, негативно воздействующие на микробактерии, к примеру, марганец. Не лейте воду, которая использовалась для промывания фильтра, в канализационную сеть.
- Проникновение в канализационную систему антибактериальных лекарств может сделать препараты для стока вовсе не полезными. Никогда не кидайте лекарственные препараты в местную канализационную систему.
Работать с бактериями лучше в перчатках
Работать с бактериями лучше в перчатках
Если же в яму все-таки попало вещество, негативно влияющее на микробактерии, или ее надо восстановить после продолжительного простоя, то следует влить в канализационную сеть чистой воды и снова добавить препарат в количестве, прописанном в инструкции.
Эти препараты выпускаются специально для стремительного роста колонии микробактерий, что даст возможность по максимуму быстро наладить функционирование септика. Если есть сомнения с выбором препарата, правильно будет обратиться к менеджеру специализированного магазина.
Использование препаратов для систем местной канализации рационально. Во-первых, сокращаются траты на обслуживание, так как малоприятную и дорогую процедуру очищения от отходов надо будет проводить в разы реже. Во-вторых, используя биопрепарат для выгребных ям и септиков, люди заботятся об окружающей среде.
Что купить для домашнего септика?

расщепляют жиры,осадочного слоя,
Гранулы в 0,1 мм, с полисахаридной оболочкой, вмещают в себя бактерии, питающиеся веществами из концентрированного раствора. Попадая в септик или яму, в надлежащих условиях, они начинают стремительно развиваются. Оболочка растворятся в жидкости, и миллионные колонии распространяются по септику с «очистительной» миссией.
Поскольку их активность зависит от многих обстоятельств, и «бойцы» биологического фронта часто погибают, поддержать армию живых организмов, призваны здоровые «новобранцы». С этой целью и определенной периодичностью в канализацию забрасываются новые десанты-капсулы со свежим пополнением.
При покупке биоактиватора нужно обращать внимание на маркировку:
- категория universal — предназначена для хозяйственных стоков;
- серия с пометкой «effect» поможет обезвредить ПАВ, жиры, агрессию порошков;
- start — активирует систему при первых сливах;
- «winter» — расконсервирует канализацию после зимы.
В том случае, если из бытовых машин выходят сливы насыщенные химией, доза увеличивается, интервалы внесения — сокращаются.
Цена начинается от 650 и устремлена к 950 рублям.
Для линии препаратов биологической активности общими являются следующие показатели:
- полное разложение отходов (99%);
- экологическая ответственность за среду обитания;
- противостояние формированию кислотно-щелочной среды с сохранением рН в пределах 5- 8;
- активность при +30С и необходимым уровнем жидкости.
Так, чтобы прочистить трубопровод от жировых частиц и засоров требуется развести 1 пакет в 9 л воды, и вылить по назначению. Такого объема хватит, чтобы промыть 50 м сантехнических изделий, а также сифоны в угловой раковине для ванной и керамической мойке. Как профилактика мероприятие проводится раз в месяц.
Виды бактерий, их плюсы и минусы
На сегодняшний день на рынке существует 3 разновидности бактерий для септиков и выгребных ям: анаэробные и аэробные бактерии, а также биоактиваторы. Основное их отличие в условиях функционирования и в методике переработки стоков. Возможен вариант комбинированной очистки септика. Сначала его обрабатывают анаэробными, а потом дополнительно аэробными бактериями.
Рассмотрим более подробно каждый из видов бактерий и выясним, какие у них существуют преимущества и недостатки.
Анаэробные бактерии
Характерная особенность этого вида бактерий состоит в том, что им не надо наличия воздуха для того, чтобы жить и размножатся. Именно по этой причине их лучше не применять для открытых выгребных ям. Оптимальный вариант использования анаэробных микроорганизмов в закрытых септиках, в которых и осуществляется полный цикл подачи – переработки — отвода жидких стоков.
В процессе переработки органические отходы превращаются в твердые остатки, которые оседают на дно, и жидкость, которой можно поливать огород. Через некоторое время, когда твердых осадков накопится немалое количество, их откачивают с помощью специальной ассенизаторской машины.
Все анаэробные бактерии в независимости от торговой марки имеют общие негативные качества:
- С течением времени, когда численность бактерий сильно возрастет, вероятней всего начнет вырабатываться метан – газ, имеющий весьма нехороший запах.
- Они не в силах очистить стоки полностью. Максимум, на который они способны – это 65%. 35% же не перерабатываются вовсе.
- Первичный отдел септика, в котором оседают твердые остатки, нужно постоянно чистить.
- Осадок необходимо утилизировать.
Аэробные бактерии
Не могут осуществлять полноценное функционирование без кислорода. Этот вариант бактерий оптимально подойдет для выгребной ямы открытого типа. Для переработки бактериями отходов в канализационной системе, надо создать специальные условия. Нужен компрессор для подачи кислорода в камеру септика, в которой функционируют микроорганизмы.
Во время переработки бактериями стоков происходит отделение углекислого газа, что провоцирует поднятие температуры в камере септика на 3-5 градусов. В резервуаре хоть и тепло, но неприятный запах отсутствует. И к тому же, аэробные бактерии способны переработать фекалии полностью, на все 100%. Осадок, который остается в результате переработки, также откачивается наружу, но его вполне можно применять как удобрение. Он полностью безопасен, поэтому нет необходимости ожидать пока он перепреет. Чаще всего огородники помещают его в компостные ямы, соединят с соломой, травой, навозом, и только тогда удобряю грунт на своем огороде.
Основные характеристики аэробных бактерий:
- Высокий уровень очистки стоков, при котором нет необходимости проводить дополнительную очистку или переработку.
- Твердый осадок можно применять как удобрение для грунта на огороде или в саду, он представлен илом, отличающимся чистотой для окружающей среды.
- Количество осадка очень малое.
- Отсутствует зловоние, при переработке стоков не выделяется метан.
- Поскольку ил образуется медленными темпами, то нет необходимости часто очищать септик.
Биоактиваторы
Этот тип очистителей для септиков и выгребных ям представляет собой сочетание бактерий и ферментов. Биоактиваторы применяют, если нужно достигнуть какой-то конкретной цели. Их подразделяют на:
- Универсальные. Подходящие для любых септиков и выгребных ям.
- Специализированные. Созданные для необходимой цели.
Их главное задание не переработка фекалий на постоянной основе, а периодическое обновления существующих бактерий, устранение загрязнений резервуара, очистка от патологических организмов и тому подобное.
В сущности, биоактиваторы – это санитары, которых применяют, чтобы восстановить эффективное функционирование бактериальных колоний.
Можно выделить такие разновидности биоактиваторов:
- Стартовые. Их применяют для того чтобы восстановить бактериальный состав после зимнего периода или если канализация долго не использовалась.
- Усиленные. Их задача – очистить чересчур загрязненные ямы. Запуск таких биоактиваторов возможен на срок до 3 недель. После этого используются анаэробные или аэробные бактерии.
- Специализированные. Применяют, чтобы очистить септик от твердых отходов и неорганики. Они очень живучие и способны переработать туалетную бумагу, ткань, картон, даже моющие средства не способны их убить.
Принцип работы аэробных септиков с биоочисткой
Аэробные септики – многокамерные очистные конструкции. Принцип работы септика этого вида — использование микроорганизмов, нуждающихся в кислороде, которые способствуют быстрому и эффективному разложению примесей. В результате образуется чистая вода, газ и ил, который удаляется через специальные люки. Этапу биоочистки предшествует осаждение наиболее крупных включений в накопительной камере.
Аэробные септики с биоочисткой часто называют станциями глубокого очищения. На выходе они дают более чистую воду (до 98% удаления примесей), а цикл осаждения и разложения примесей в них существенно меньше, чем в моделях иного типа.
 Принцип работы септика с глубокой биологической очисткой позволяет в дальнейшем использовать очищенную воду для технических нужд
Принцип работы септика с глубокой биологической очисткой позволяет в дальнейшем использовать очищенную воду для технических нужд
Из-за необходимости обеспечивать постоянный приток воздуха все аэробные септики являются энергозависимыми, а их устройство и эксплуатация требуют дополнительных средств (расходы на электроэнергию), однако тщательные расчеты доказывают окупаемость подобных инвестиций при постоянном использовании.
При эксплуатации аэробных септиков с биоочисткой следует соблюдать следующие рекомендации:
- Колония перерабатывающих примеси микроорганизмов может погибнуть, если слить в канализацию большое количество дезинфицирующего средства или антисептика.
- Причиной гибели микроорганизмов может стать и перерыв в эксплуатации, поэтому модели данного типа больше подходят для домов с постоянным проживанием, чем для дач.
Топ-5 бактерий для септиков и выгребных ям
Концентрированная суспензия Бионекс Септик Трит
Препарат состоит из 8 отдельных аэробных и анаэробных бактерий. В процессе работы средства не происходит выделение газов имеющих плохой запах, отходы не перегнивают. Бактерии, составляющие Бионекс, не погибают под воздействием агрессивной среды. То есть продолжают функционировать даже после контакта с бытовой химией. Если использовать биопрепарат постоянно, то бактерии заселяют всю поверхность канализации, как бы создавая защитную пленку. Происходит не только устранение загрязнений, которые уже присутствуют, а предотвращение появления новых.
Для того чтобы добиться наилучшей результативности препарата, необходимо использовать его ежедневно, соблюдая рекомендации и дозировку, указанные в инструкции. Перед применением средство необходимо развести его с отстоянной водой и потом дать раствору постоять на протяжении суток.
Биопрепарат «Водограй»
В состав средства входят живые аэробные микроорганизмы в высушенном состоянии. Если правильно выполнять рекомендации по применению препарата, то под его воздействием прекрасно перерабатываются фекалии, жировые отложения, туалетная бумага и другие органические отходы.
После использования средства в твердом состоянии остается лишь 4% отходов. Благодаря этому яму или септик необходимо чистить крайне редко. Применение биопрепарата не позволяет отлаживаться илу, растворяет жировую пленку.
Если вы применяете бактерии первый раз, то необходимо каждый месяц обновлять их наличие, чтобы фекалии и бытовые отходы перерабатывались как можно быстрее. Информация о длительность использования и дозировке повторного применения указана в инструкции.
Атмосбио
Это средство относится к ограниченному числу препаратов, которые не требуют предварительной активации. Нужно всего лишь засыпать пачку средства в унитаз, несколько раз смыть его и примерно спустя 6-8 часов бактерии начнут свое функционирование. В состав препарата входят энзимы и грунтовые микроорганизмы. Благодаря такому сочетанию отходы быстро перерабатываются. Если среда неблагоприятная для существования бактерий, то они не уничтожаются, а адаптируются, на определенное время, затормаживая свои процессы жизнедеятельности.
Препарат отлично устраняет корки, осадок на дне и жировую пленку. Видимый эффект действия средства появляется примерно спустя 14 дней.
В упаковке содержится 24 пакетика средства. Препарат необходимо использовать в расчете 1 пакетик на неделю. В результате, полноценно колония бактерий образуется и начнет работать спустя 60 дней.
Санекс
Это мощнейший биопрепарат, действие которого направлено на разложение не только фекалий и других органических отходов, а и на остатки неорганической природы, жиры и тому подобное. Производится и разрабатывается Санекс канадской компанией.
Применять его можно для очистки каких угодно септиков и выгребных ям. После его работы практически не остается твердых остатков. Их количество составляет всего 3%. Стограммовой упаковки средства будет достаточно, чтобы поддерживать функционирование микроорганизмов на протяжении года при начале использования и на период 1,5 года при повторном применении.
Санекс прекрасно справляется с возложенными на него задачами, как в летний, так и в зимний период. Только внимательно следите за тем, чтобы поверхность стоков не была сухой. Количество воды в резервуаре септика или выгребной яме должно хотя бы на 2 см превышать твердые отходы.
Доктор Робик
Это средство от российского производителя совмещает в себе 6 разновидностей бактерий, способных разлагать все органические отходы и некоторые неорганические, к примеру, ткань, бытовую химию. Противостоит созданию корочек на стенках канализации, не позволяет илу отлаживаться на дне. Количество твердых остатков после переработки не превышает показатель 3-4%. Через 2-3 дня после применения препарата исчезает зловоние, а примерно через 14 дней существенно снижается уровень стоков в септике или выгребной яме.
Средство Доктор Робик требует активации заранее. Количество бактерий нужно постоянно обновлять, в противном случае существующие микроорганизмы «впадают в спячку».
Флакона с препаратом будет достаточно на год применения. Средство не работает в условиях отрицательных температур.
Общие свойства для аэробов и анаэробов
- Все эти прокариоты не имеют выраженного ядра.
- Размножаются или почкованием, или делением.
- Осуществляя дыхание, в результате окислительного процесса, как аэробные, так и анаэробные организмы разлагают огромные массы органических остатков.
- Бактерии являются единственными живыми существами, чье дыхание связывает молекулярный азот в органическое соединение.
- Аэробные организмы и анаэробы способны осуществлять дыхание в широком диапазоне температур. Существует классификация, согласно которой безъядерные одноклеточные организмы подразделяют на:
психрофильные – условия жизни в районе 0°С;
Организмы, которые способны получать энергию в условиях отсутствия кислорода, называются анаэробами. Причём к группе анаэробов относятся как микроорганизмы (простейшие и группа прокариотов), так и макроорганизмы, к которым можно отнести некоторые водоросли, грибы, животных и растения. В нашей статье мы подробно рассмотрим анаэробные бактерии, которые используются для очистки сточных вод в локальных очистных сооружениях. Поскольку наряду с ними в очистных сооружениях могут применяться аэробные микроорганизмы, мы проведём сравнение этих бактерий.
Что такое анаэробы, мы разобрались. Теперь стоит понять, на какие виды они делятся. В микробиологии используется следующая таблица классификации анаэробов:
-
Факультативные микроорганизмы
. Факультативно-анаэробными называют бактерии, которые могут менять свой метаболический путь, то есть способны менять дыхание с анаэробного на аэробное и наоборот. Можно утверждать, что они живут факультативно. -
Капнеистические представители группы
способны жить только в среде с пониженным содержанием кислорода и повышенным содержанием углекислого газа. -
Умеренно-строгие организмы
могут выживать в среде с содержанием молекулярного кислорода. Однако тут они не способны размножаться. Макроаэрофилы могут и выживать, и размножаться в среде с пониженным парциальным давлением кислорода. -
Аэротолерантные микроорганизмы
отличаются тем, что они не могут жить факультативно, то есть не в состоянии переключаться с анаэробного дыхания на аэробное. Однако от группы факультативно-анаэробных микроорганизмов они отличаются тем, что не гибнут в среде с молекулярным кислородом. В эту группу входит большинство маслянокислых бактерий и некоторые виды молочнокислых микроорганизмов. -
Облигатные бактерии
быстро гибнут в среде с содержанием молекулярного кислорода. Они способны жить только в условиях полной изоляции от него. В эту группу входят инфузории, жгутиковые, некоторые виды бактерий и дрожжи.
Общие методы культивирования для анаэробных организмов
GasPak — система химическим путем обеспечивает постоянство газовой смеси, приемлемой для роста большинства анаэробных микроорганизмов. В герметичном контейнере, в результате реакции воды с таблетками боргидрида натрия и бикарбоната натрия образуется водород и диоксид углерода . Водород затем реагирует с кислородом газовой смеси на палладиевом катализаторе с образованием воды, уже вторично вступающей в реакцию гидролиза боргидрида.
Данный метод был предложен Брюером и Олгаером в 1965 году. Разработчики представили одноразовый пакет, генерирующий водород, который был позднее усовершенствован ими до саше, генерирующих двуокись углерода и содержащих внутренний катализатор.
Метод Цейсслера применяется для выделения чистых культур спорообразующих анаэробов. Для этого производят посев на среду Китт-Тароцци, прогревают 20 мин при 80 °C (для уничтожения вегетативной формы), заливают среду вазелиновым маслом и инкубируют 24 ч в термостате. Затем производят посев на сахарно-кровяной агар для получения чистых культур. После 24-часового культивирования интересующие колонии изучаются — их пересеивают на среду Китт-Тароцци (с последующим контролем чистоты выделенной культуры).

Метод Фортнера
Метод Фортнера — посевы производят на чашку Петри с утолщенным слоем среды, разделённым пополам узкой канавкой, вырезанной в агаре. Одну половину засевают культуру аэробных бактерий, на другую — анаэробных. Края чашки заливают парафином и инкубируют в термостате. Первоначально наблюдают рост аэробной микрофлоры, а затем (после поглощения кислорода) — рост аэробной резко прекращается и начинается рост анаэробной.
Метод Вейнберга используется для получения чистых культур облигатных анаэробов. Культуры, выращенные на среде Китта-Тароцци, переносят в сахарный бульон. Затем одноразовой пастеровской пипеткой материал переносят в узкие пробирки (трубки Виньяля) с сахарным мясо-пептонным агаром, погружая пипетку до дна пробирки. Засеянные пробирки быстро охлаждают, что позволяет фиксировать бактериальный материал в толще затвердевшего агара. Пробирки инкубируют в термостате, а затем изучают выросшие колонии. При обнаружении интересующей колонии на её месте делают распил, материал быстро отбирают и засеивают на среду Китта-Тароцци (с последующим контролем чистоты выделенной культуры).

Метод Перетца
Метод Перетца — в расплавленный и охлаждённый сахарный агар-агар вносят культуру бактерий и заливают под стекло, помещённое на пробковых палочках(или фрагментах спичек) в чашку Петри . Метод наименее надежен из всех, но достаточно прост в применении.
Популярные препараты
К группе популярных средств относятся септики: «Бриз», «Водограй» «Илеть», «Грин рок», с содержанием стеклопластика — «Полекс», накопительные — «Элгард», «Аква», «Санекс», «Кедр» и ряд других. Стоимость порошка в пакетике (100 г) начинается от 100 руб.

ВioforceТопасАстрабыстро избавит не только от запахов,1800 руб.
Септик «BIOFORCE» порадует растворимыми пакетиками с хвойным ароматом, упаковки в 675 г хватит на год, микрофлора активатора устоит перед градусами в минус.
Универсальная формула из ферментов и простейших подойдет для использования в любых условиях. При постоянном использовании активатора не образуются засоры в канализации, в меньшей степени оседает твердый ил. Он активен в аэробном и анаэробном септиках.
При использовании препарата имейте в виду некоторые факторы:
- концентрацию;
- пропорции;
- покупайте продукт с небольшим сухим остатком (указан в процентах производителем).
Качество и формулы продукции совершенствуются, и рынок предлагает новые товары, появляющиеся благодаря новым разработкам в биотехнологии. Поэтому не останавливайтесь на одном септике, и ищите выгодный вариант по соотношению стоимости и функциональности.
Самодельный или покупной
Преимущества готового устройства:
- Простота установки – самостоятельный или при помощи специалистов монтаж в подготовленный котлован.
- Подключение к канализационной системе и быстрое включение системы в работу.
- Без необходимости строительства.
Недостаток – высокая стоимость.
Строительство самодельного септика производится из желания сэкономить. Очистительную модель возводят из автошин, бетонных колец, кирпича. Однако, подобная модель подойдет при сезонном проживании. Кроме того, запуск конструкции в работу потребует больших временных затрат. Поэтому, рациональный вариант – приобретение готового устройства.
Какие бактерии для выгребных ям лучше
Однозначно сказать «покупайте этот препарат и все будет работать» не может никто. Одни и те же средства у одних работают на отлично, у других — средне, у третьих — почти не работают. Возможные причины описали выше, но может еще все зависит от вида отходов, которые попадают в яму. На даче там будет немного химии, зато, скорее всего, много органики и бактерии будут более активны. В домашних стоках химических средств больше, в результате тот же препарат может быть уже не настолько эффективен, зато другой будет работать очень хорошо.
Один из эффективных препаратов — Санэкс
В общем, что можно посоветовать — пробуйте разные препараты, начиная с дешевых. Какой-то из них вам поможет. Есть, кстати, одна хитрость, которая поможет активизировать процессы переработки. Периодически выливайте в сточную яму просроченный кефир или скисшее молоко, можно высыпать пакет-другой манки. Бактерии любят белок, а его в отходах немного. Подкормив их вы стимулируете развитие колонии, процесс разложения пойдет быстрее.
| Название | Температура применения | Фасовка | На какой объем | Стартовая загрузка | Регулярная месячная загрузка | Тип препарата | Кислотность среды | Работа зимой | Страна-производитель | Цена |
|---|---|---|---|---|---|---|---|---|---|---|
| Биоэнзим БИО-Р1 | от 5°C до 40°C | 1 пакет 100 г | до 4 м3 | 200 г (2 упаковки) | 100 г (одна упаковка) | смесь бактерий | PH = 5,0 — 7,5 | Работает на двойной дозе | Чехия | 6-7$ |
| Биосепт 600 | от 5°C до 40°C | 24 пакета по 25 г | до 4 м3 | 4 пакета (100 г) | 2 пакета (50 г) | смесь бактерий | PH = 5,0 — 7,5 | в спящем состоянии | Франция | 20$ |
| ORO-fresh WC-Aktiv | от 5°C до 60°C | 12 пакетов по 25 г | до 4 м3 | 4 пакета (100 г) | 2 пакета (50 г) | смесь бактерий | PH = 4,0 — 10 | в спящем | Германия | 12$ |
| Водограй | от 30°C до 40°C | до 2 м3 | 100 гр | 20 г | Украина | 12$ | ||||
| EPARCYL (Эпарсил) | 22 пактета по 32 г | до 2 м3 | 2 пакета (64 г) | 1 пакет (32 г) | смесь бактерий | Франция | 30$ | |||
| Санэкс | от 5°C до 45°C | 400 г + мерная ложка | до 2 м3 | 2-5 мерных ложки | 2 мерных ложки | смесь бактерий и ферментов | PH = 5 — 8,5 | Работает при положительных температурах в яме | Польша | 12$ |
| (SEPTIFOS) Септифос | от +2°С до +40°С | 18 пакетиков по 25 г | до 2 м3 | 3 пакетика (75 г) | 2 пакета (50 г) по одному два раза в месяц | 27,5$ | ||||
| Микрозим Септи Трит | +2 до 45°С | 250 гр | 1-2 м3 | 250 гр | 50-100 г | смесь бактерий | pH = 5 — 9 | в спящем состоянии | Россия | 12$ |
| биопрепарат Удачный | 30 гр | 0,5 м3 | 1 пакет каждую неделю | 1 пакет | смесь бактерий | Россия | 1,2$ | |||
| БИОТЕЛ | от 4°C | 25 гр | 1 м3 | 5-7 гр раз в день | бактериально-ферментный состав | в не щелочную среду | неактивны | Россия | 1 $ | |
| Атмосбио | от 5°C до 40°C | 24 пакета по 25 гр | 1 м3 | 5 пакетиков | 1 пакет в неделю | смесь бактерий и энзимов | Франция | 17$ | ||
| Septic System Mainteiner DWT-360 Майнтейнер DWT-360 SSM | от 5°C до 40°C | 454 гр | до 2 м3 | 3 мерных ложки | 1 мерная ложка | смесь бактерий | США | 30-40$ | ||
| Доктор Робик Roebik 109 | от 5°C до 40°C | 1 пакет 75 г | 1,5 м3 | 1 пакет 75 г | 1 пакет 75 г | смесь бактерий | Россия | 1,8$ | ||
| Доктор Робик Roebik 509 для переполненных и старых ям | от 5°C до 40°C | 798 мл (жидкость) | 1,5 м3 | разовое применение | концентрат | Россия | 14$ |
Есть пара замечаний по поводу средств для дачных туалетов «доктор Робик». Это продукция американской фирмы, но у них есть завод в России. Препараты российского производства называются Roebik, американского Roetech. Разница в цене довольно существенная. Раньше и отечественный Робик работал отлично, так что не было смысла переплачивать, но в последний год ситуация ухудшилась, так что стоит подумать.
Любой из списка препаратов имеет неплохие отзывы. Сказать, что все они положительные нельзя, но большая часть говорит о хороших результатах. Чтобы бактерии для выгребных ям и дачных туалетов не разочаровали, надо покупать их не на рынке а в магазине. Тут больше шансов того, что будут соблюдаться правила хранения. А чтобы не купить подделку желательно покупать у официальных представителей кампании. Информацию об этом можно найти на сайте производителя в разделе «Где купить».
Аэробный способ
Аэробное очищение сточных вод происходит при участии бактерий и кислорода. В результате такой деятельности выделяется:
- вода;
- углекислый газ;
- тепловая энергия.
Это приводит к увеличению активного ила, который формируется из колоний микроорганизмов.
Аэробный процесс очищения включает несколько этапов:
- Фильтрация воды от твердых частиц.
- Окисление органики. В итоге образуется активный ил – осадок, состоящий из колоний бактерий. Он поступает в отдельный отсек.
- Переработка и обеззараживание полученного осадка.
Процесс очищения происходит в биореакторе. Это емкость, изготовленная из пластика, бетона или металла. На дне биореактора располагаются сита, в которых находятся сами микроорганизмы.
Доступ к кислороду обеспечивают аэраторы – перфорированные трубы. Когда по ним проходит воздух, сточные воды насыщаются кислородом.
Важно! Активный ил, полученный аэробным путем, нуждается в утилизации.
В процессе жизнедеятельности бактерий происходит выброс тепловой энергии. В итоге повышается температура всей системы. Это может привести к гибели микроорганизмов.
Для контроля над микроклиматом обязательно устанавливают датчики и систему управления. Существенные затраты электроэнергии идут на поддержание работы воздуходувок.
Особенности аэробных устройств:
- удаление свыше 99% ХПК;
- 1 кг загрязнений дает 0,4 кг активного ила;
- не образуется биогаз;
- для ликвидации 1 кг загрязнений потребление электричества составит 5 кВтч.
Эффективность аэробных методов снижается под воздействием ряда факторов:
- наличие токсичных веществ и солей тяжелых металлов;
- работа с загрязнениями, которые долго окисляются;
- большие габариты;
- высокая концентрация активных веществ, замедляющих деятельность микроорганизмов;
- температура, выходящая за пределы 20-30 градусов;
- нарушение кислотно-щелочного баланса, который установлен для каждого вида бактерий.
Указанные факторы угнетают деятельность микроорганизмов или приводят к их полной гибели. Поэтому при выборе аэробного метода обязательно учитывают, какие компоненты содержатся в сточных водах.
Аэробный метод обеспечивает повышенное качества обработки. После очищения разрешено сбрасывать водную массу в реки и водоемы.
Для строительства аэробных конструкций нужно больше свободного пространства и значительные вложения.
Самостоятельная установка септика
Подготовка котлована
Выполнив все подготовительные работы, приступаете к рытью котлована. Его размер должен быть больше заданного объема септика. Учитывайте толщину стенок и дна колодца. Далее приступаете к строительству емкости:
- На дно ямы насыпаете слой песка толщиной 15 см и хорошо утрамбовываете его. После чего заливаете бетон, слоем 15 см.
- После того как бетон схватится, приступайте к строительству стен. Для кладки можно использовать шлакоблок или кирпич. Но в случае отсутствия таких материалов, придется строить опалубок и выливать бетоном стены. Для конструкции опалубки подойдут любые доски, фанера, жесть. Одну сторону стенки будет выполнять грунт ямы, а другую сбейте из подручного материала. В середине конструкции поставьте распорки, чтобы бетон ее не раздавил. Было бы целесообразно изготовить опалубку с учетом размера камер, чтобы перегородки тоже были из бетона и вставить гильзы в тех местах, где будут проходить переливная, входная и выходная трубы.
- В готовый каркас начинайте заливать бетон, периодически армируя конструкцию арматурой. Ее устанавливаете как вертикально, так и горизонтально, по всему периметру каркаса. После полной заливки даете конструкции 2 недели на застывание.
- С застывшего бетона снимаете все щиты и приступаете к строительству перегородки (если вы их не сделали сразу). Яма должна быть разделена на две камеры. Первая камера, в которую будут попадать сточные воды, должна быть больших размеров. Перегородку строите из кирпича или шлакоблока с окном для переливания из отстойника в другую камеру.
- Закончив строительство, выполните гидроизоляцию стенок горячим битумом или купленной мастикой.
- Если это не сделано на этапе заливки бетона, то в местах входа канализации и выхода дренажной трубы пробейте перфоратором отверстия. После вставки труб, зазор загерметизируйте силиконом.
- Крышку для ямы можно изготовить из листового металла, деревянных щитов и т.д.
- Выходная труба идет к полю фильтрации.


















































